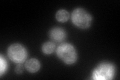
YDL232W
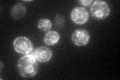
YDL232W

View description
Subunit of the oligosaccharyltransferase complex of the ER lumen, which catalyzes protein asparagine-linked glycosylation; type I membrane protein required for incorporation of Ost3p or Ost6p into the OST complex
Localization:
Intensity:
Fold change:
Significance:
-
C’ GFP library in SD

ER116.17 -
N' NOP1pr-GFP in SD

ER,punctate0 -
N' TEF2pr-mCherry in SD

mitochondria464.003 -
N' NATIVEpr-GFP in SD

punctate17.8117 -
N' TEF2pr-VC and Cyto-VN in SD

below threshold24.0077 -
C’ GFP library in SD+DTT
ER128.571.1No -
C’ GFP library in SD+H2O2

ER116.181No -
C’ GFP library in Starvation Media
ER119.131.02No -
C’ GFP library on the background of Pup2-DaMP

N/A -
C’ GFP library on the background of CCT mutant

N/A0N/AYes
